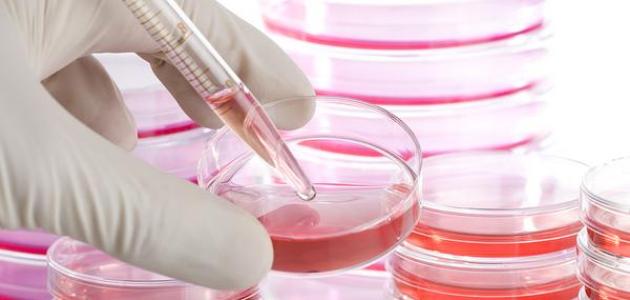
ما هي الخلايا الجذعية ما هي الخلايا الجذعية

محتويات
تُعرّف الخلايا الجذعية (بالإنجليزية: Stem Cells) على أنّها خلايا غير مُتمايزة قد تنقسم لإنتاج بعض الخلايا التي تستمر كخلايا جذعية أو تصبح خلايا متخصصة (بالإنجليزية: Specialized)، وتُمثّل الخلايا الجذعية مصدراً مُستمراً لتزويد الجسم بالخلايا المُتمايزة المسؤولة عن تشكيل الأنسجة والأعضاء ليس في جسم الإنسان فحسب وإنّما لدى النباتات أيضاً.[١]
تُقسم الخلايا الجذعية إلى أربعة أنواع رئيسية بالاعتماد على مصدرها وقدرتها على التمايز، وفيما يلي بيان لذلك:[٢]
يتم الحصول على الخلايا الجذعية الجنينية (بالإنجليزية: Embryonic stem cell) من كتلة الخلايا الداخلية الخاصة بالكيسة الأُريميَّة للجنين (بالإنجليزية: Blastocyst) والتي تكون مسؤولة عن إنتاج خلايا أكثر تخصصاً، بحيث تؤدي إلى ظهور جميع أنواع الخلايا الخاصة بأعضاء وأنسجة الجسم المختلفة، ويُمكن استخراج كتلة الخلايا الداخلية وإنمائها في ظروف مخبرية خاصة تُمكّنها من الاحتفاظ بخصائص الخلايا الجذعية الجنينية، حيث تكمن أهمية الخلايا الجذعية الجنينية في أنّها تُمكّن من دراسة التطور الطبيعي، وحدوث الأمراض، إضافة إلى اختبار الأدوية والعلاجات الأخرى.[٣]
يُطلق على الخلايا الجذعية البالغة (بالإنجليزية: Adult Stem Cells) أيضاً مصطلح الخلايا الجذعية المطابقة لنوع النسيج (بالإنجليزية: Tissue-specific stem cells) وتكون قادرة على توليد أنواع مختلفة من خلايا النسيج أو العضو الذي تعيش فيه كخلايا الجلد مثلاً، وهذا ما يجعلها أكثر تخصصاً مقارنة بالخلايا الجذعية الجنينية، فعلى سبيل المثال لا الحصر تكون الخلايا الجذعية المكوّنة للدم قادرة على توليد خلايا الدم الحمراء، وخلايا الدم البيضاء، والصفائح الدموية، ولكنّها لا تكون قادرة على توليد خلايا الأنسجة والأعضاء الأخرى مثل خلايا الكبد، أو الدماغ، أو الرئة. وتجدر الإشارة إلى وجود أنواع من الخلايا الجذعية البالغة الموجودة في بعض أنسجة وأعضاء الجسم، والتي تكون قادرة على استبدال الخلايا المفقودة من النسيج في الحياة اليومية العادية أو عند التّعرض لإصابة ما، ومن الأمثلة عليها الخلايا الجذعية الميزنكيمية (بالإنجليزية: Mesenchymal Stem Cells) التي يُطلق عليها أيضاً مصطلح الخلايا السدوية (بالإنجليزية: Stromal cells) وهي تُمثّل الخلايا المعزولة من النسيج الضام المُحيط بالأنسجة والأعضاء. وقد مكّنت الخلايا الجذعية البالغة من زيادة معرفة الإنسان بالأمور المُتعلّقة بالتطور الطبيعي، والتغيرات التي تحدث مع التّقدم في العمر، والأمور التي تطرأ عند التّعرض لإصابة أو مرض مُعين.[٣]
تُمثّل الخلايا الجذعية المستحثة متعددة القدرات (بالإنجليزية: Induced pluripotent stem cells) نوعاً من الخلايا المُهندّسة في المختبر من خلال تحويل الخلايا الجذعية البالغة إلى خلايا تشابه في سلوكها الخلايا الجذعية الجنينية، وهذا ما قد يجعلها قادرة على توليد جميع أنواع الخلايا في الجسم. وقد مكّنت هذه الخلايا العلماء من التّعرف بشكل أكبر على التطور الطبيعي، وحدوث الأمراض وتطورها، واختبار الأدوية والعلاجات الأخرى وتطويرها.[٣]
يُمكن الحصول على الخلايا الجذعية من الدم المحيطيّ (بالإنجليزية: Peripheral Blood Stem Cells) من خلال عينة من الدم، إذ تكون هذه الخلايا قادرة على إنتاج عدد كبير من الخلايا ذات الوظائف المختلفة والتي تشكل الدم وجهاز المناعة، بما في ذلك خلايا الدم الحمراء، والصفائح الدموية، والخلايا الحبيبية (بالإنجليزية: Granulocytes)، والخلايا الليمفاوية.[٢]
يمكن الحصول على خلايا الحبل السري الجذعية (بالإنجليزية: Umbilical Cord Stem Cells) من الأطفال حديثي الولادة، وتُعتبر هذه الخلايا متعددة القدرات؛ أي إنّها قادرة على التمايز إلى أنواع معينة من الخلايا وليس جميع الأنواع، وهذا ما دفع الأطباء والعلماء إلى تخزين دم الحبل السري عند ولادة الطفل نظراً لاحتمالية استخدامه في المستقبل في حال حاجة الفرد إلى العلاج بالخلايا الجذعية.[٢]
اهتمّ الباحثون والأطباء بتقنية الخلايا الجذعية لما لها من فوائد عديدة، نذكر منها ما يلي:[٤]
- تُسهم الخلايا الجذعية في فهم واستيعاب كيفية حدوث الأمراض وتطورها من خلال متابعة نمو وتطور الخلايا الجذعية في الأعضاء والأنسجة المختلفة من الجسم.
- يمكن استخدام بعض أنواع الخلايا الجذعية في اختبار فعالية وسلامة الأدوية الجديدة، إذ يُمكن معرفة مدى فعالية دواء جديد بدقة عن طريق اختبار تأثيره على نسيج مُحدد.
- تُستخدم الخلايا الجذعية في مجال الطب التجديدي (بالإنجليزية: Regenerative Medicine) بهدف توليد خلايا سليمة لتحل محل الخلايا المريضة وذلك من خلال توجيه الخلايا الجذعية لتصبح خلايا متخصصة يُمكن استخدامها لاستبدال الأنسجة المريضة أو التالفة في جسم الإنسان، ويُمكننا القول بأنّ الخلايا الجذعية تكون قادرة في هذه الحالة على تشكيل نسيج جديد، وقد مكّن استخدام الخلايا الجذعية من علاج العديد من الحالات المرضية، ومن الأمثلة على ذلك:
- إصابات النخاع الشوكي.
- مرض باركنسون (بالإنجليزية: Parkinson’s disease)، والزهايمر (بالإنجليزية: Alzheimer’s disease).
- السكري من النوع الأول، وأمراض القلب، والسكتة الدماغية، إضافة إلى التهاب المفصل التنكسي (بالإنجليزية: Osteoarthritis).
- بعض أمراض الدم، حيث تُستخدم الخلايا الجذعية الخاصة بالدم حالياً في علاج بعض الحالات، مثل توفير مصدر لخلايا الدم السليمة للأشخاص الذين يعانون من بعض أمراض الدم، مثل الثلاسيميا (بالإنجليزية: Thalassemia) ومرضى السرطان الذين فقدوا هذه الخلايا خلال فترة العلاج.[٥]
- بعض مشاكل الجلد، حيث استُخدمت الخلايا الجذعية الخاصة بالجلد لتوليد بشرة جديدة للأشخاص الذين يعانون من حروق شديدة.[٥]
- يُمكن استخدام الخلايا الجذعية لتوليد أعضاء جديدة لاستخدامها في عمليات زراعة الأعضاء، إذ إنّ ذلك يُقلل من احتمالية رفض العضو المزروع نتيجة مهاجمة الجهاز المناعي للجسم له.[٥]
- ↑ “Stem cell”, www.britannica.com, Retrieved 3-6-2018. Edited.
- ^ أ ب ت “Stem Cells”, www.medicinenet.com, Retrieved 3-6-2018. Edited.
- ^ أ ب ت “Types of Stem Cells”, www.closerlookatstemcells.org, Retrieved 3-6-2018.
- ↑ “Stem cells: What they are and what they do”, www.mayoclinic.org, Retrieved 3-6-2018. Edited.
- ^ أ ب ت “What is a stem cell?”, www.yourgenome.org, Retrieved 3-6-2018. Edited.









